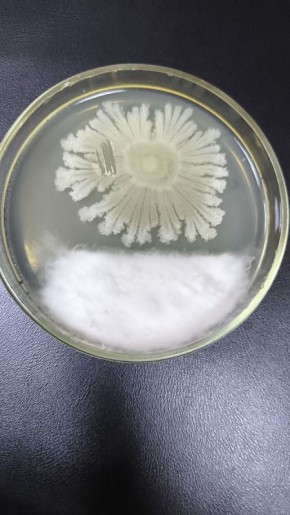
Солнышко сражается с фузариумом и защищает растения

Серия взрывов прогремела в пригороде Краснодара и Северском районе края, – издание SHOT.
Предварительно, ПВО отражает воздушную атаку по украинским БПЛА.
SHOT пишет, что минимум 7 взрывов было слышно в южной части Краснодара, в нескольких населённых пунктах Северского района и рядом с посёлком Яблоновский. Также местные утверждают, что видели яркие вспышки в небе и слышали звук мотора. По предварительным данным, ПВО работает по украинским БПЛА.